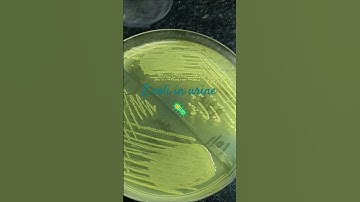
E.coli in urine #uti #urinaryinfection #urinarytractinfections #bacteria #bacterialculture

⬇ DOWNLOAD NOW
Kalau muncul iklan pop-up, tutup lalu klik tombol kembali
Download lagu E.coli #laboratory #science #laboratorytechniques #lab #research #researchlab #shorts #labtechnition secara gratis hanya untuk keperluan promosi. Dukung artis favorit kamu dengan membeli musik original di iTunes atau platform resmi lainnya.
 The thrill of basic science | #Shorts #YouTubeShorts #Research #lab #science #STEM
The thrill of basic science | #Shorts #YouTubeShorts #Research #lab #science #STEM
 What is E.coli?|E.coli|E.coli bacteria|Bacteriology|Microbiology|microorganisms#shorts#microbiology
What is E.coli?|E.coli|E.coli bacteria|Bacteriology|Microbiology|microorganisms#shorts#microbiology
E.coli in urine #uti #urinaryinfection #urinarytractinfections #bacteria #bacterialculture
E.coli in urine #uti #urinaryinfection #urinarytractinfections #bacteria #bacterialculture
 Top 4 E. Coli Experiments #shorts
Top 4 E. Coli Experiments #shorts
 Genetically Modifying Bacteria Speed Run
Genetically Modifying Bacteria Speed Run
 Biochemical Test of bacteria #bacteriology #health #laboratory #shorts
Biochemical Test of bacteria #bacteriology #health #laboratory #shorts
 Day in the Life of a Medical Laboratory Technician
Day in the Life of a Medical Laboratory Technician
 E coli lab diagnosis | Escherichia coli | Laboratory | Steps | Diagmosis #trending #bacteriology
E coli lab diagnosis | Escherichia coli | Laboratory | Steps | Diagmosis #trending #bacteriology